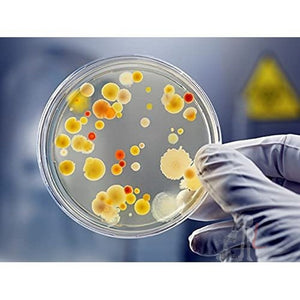
Scifa High Quality Borosilicate Glass Petri dish - 100 mm Pack of 5 - Laboratorydeal

Scifa High Quality Borosilicate Glass Petri dish - 100 mm Pack of 5
Ask a question
Wordwide Delivery
Fast shipping on all orders
Return within 10 days of purchase. Duties & taxes are non-refundable.
Guaranteed Safe Checkout
Scifa High Quality Borosilicate Glass Petri dish - 100 mm Pack of 5
Description
Petri dish
Brand: Scifa
Color: Transparent
Features:
- Size: 100mm diameter, 17mm height
- Heavy duty borosilicate glass petri dish
- Autoclavable, can withstand direct flames and harsh chemicals
- Can withstand wet or dry repeated sterilisation
- Beaded edges for greater mechanical strength
model number: Petri dish_100 mm_5
Part Number: Petri dish_100 mm_5
Details: Borosilicate glass, can withstand wet or dry repeated sterilization. The edges are beaded to provide greater mechanical strength. The heavy borosilicate glass is auto clavable and can handle direct flames
Return Policies
Privacy Policy
Thank you for visiting our e-commerce portal laboratorydeal.com. This Privacy Policy contains information about laboratory deal commitment to your privacy.
7 Days Easy Returns
- If not satisfied with item quality, size or delivery
- only replacement not refund or other product purchase same amount .
- Models, Chemicals, filter papers And Glasswares no Return Policy . if you any receive Damage product ,please not accept Parcel .or same date complaint :info@laboratorydeal.com or whatsapp: 9708417194 , courier slip mention damage .
Note: This Privacy Policy applies only to Websites operated or controlled by laboratory deal, and not to Aajjo offline practices. This Privacy Policy does not apply to the Websites of other companies, individuals, or organizations to which we may deliver hyperlinks or that laboratory deal may be affiliated with, but are not directly under Aajjo maneuver or control. These Websites may have different policies relating to your privacy and the information
What information does laboratory deal ccumul from visitors to its Website? How does Aao use that information? They just gather about you. Visitors should refer to the privacy policies of such Websites, as laboratory deal has no control over information that is submitted to, or collected by, third parties.
Our Website collects two kinds of information from you:
1.Personally Identifiable Information
We collect and utilize personally identifiable information about you when you submit feedback, questions, or requests for information about laboratory deal's products and services, apply for a job or make a purchase. This may comprise your name, mailing address, telephone number, fax number, e-mail address and other information in order to respond to your inquiries and manage transactions with you. Laboratory deal may accumulate and store the information you pick out to provide us to send you information about laboratory deal our affiliates, including information about Our Products and services, from time to time. We may also use information about you for internal marketing analysis to better understand our customers and the open market.
2.Information Sharing
We may share personal information that we gather through our Website with carefully selected third parties, including our affiliates, dealers, distributors, partners and sponsors whose products or services we consider may be of interest to you. If you do not want us to share information about you in this manner, please see the section below titled, “What other choices do I have concerning information collected from me?”
Aajjo may also share personally identifiable information about you with third parties that help manage our Website or provide data processing, order fulfillment, or shipping services, or that provide other services on our behalf.
As laboratory deal continues to advance its business, we may go into transactions to sell our assets or to buy or sell holdings or business units. As part of these transactions, personal information covered by this Privacy Policy may be one of the transferred assets.
Finally, Aajjo keeps the right to unveil personal and non-personal information about you if Aajjo realistically believes it is necessary to do so by law, including court order, to protect Aajjo or the rights of others, or to lower the risk of credit or other kind of fraud.
3.Third Party Links
This Website may contain hyperlinks to other Websites. Additionally, third parties may from time to time deliver hyperlinks to our Web site. PLEASE BE AWARE THAT WE ARE NOT RESPONSIBLE FOR THE CONTENT OR PRACTICES OF ANY THIRD PARTY WEB SITE. We embolden our users to read the privacy policies of the Web sites that they visit.
How can I change what promotional communications I receive?
If you would like to opt-out of receiving promotional e-mail messages from us, please send an e- mail to info@laboratorydeal.com Please include your name and e-mail address in the body of the e-mail and reference “Remove” on the subject line. Please note that it may take a reasonable period of time for us to process opt out requests.
What other choices do I have about information collected over the Web sites?
If you do not want to us to share information with third parties as described under the heading, “Information Sharing,” please send an e-mail info@laboratorydeal.com
How can I update personal information earlier provided to laboratory deal?
If you would like to change or modify information you have previously provided to Aajjo through our Web sites, please send an e-mail to info@laboratorydeal.com. Please note that we may not be able to make certain changes for legal reasons or to reserveprecise records of transactions.
How does SEABIRD secure personal information collected through its Web sites?
We employ realistic security measures to protect against the loss, mistreatment, or variation of personal information we gather through our Web sites.
Children under the age of 13.
Our Web site is not targeted to children under the age of thirteen, and we do not perceptively ask for, collect, or use personally identifiable information from any child under the age of thirteen. If we turn out to be aware that we have involuntarily received personally identifiable information from a user under the age of 13, we will punctually delete the information from our records.
Refund Policy
- 7 -10 Day Refund and courier charges will be deducted and refunded
- Return parcel pick facility only some pin codes , self shipment order no pickup facility provide . return India post service
- Only prime parcel 30 days return.and FREE shipping only prime members . Conditions apply.
100% Payment Protection
- Not satisfied with your purchase?
- Facing an issue with your item?
- Get 100% payment protection on your purchases.
- courier charge not refund
- 45 days you have no received parcel please complaint file or order cancellation and email complaint@laboratorydeal.com then company refurnd payment.
Refund Modes
We will initiate refund to the following modes once your item is received by us or the seller:
| Payment mode | Refund mode options |
|---|---|
| Credit card/ Debit card/ Prepaid Payment Instrument | Credit card/ Debit card/ Prepaid Payment Instrument / |
| Bank Account through net banking | Bank account through net banking/ |
| Cash on Delivery* | NEFT to Bank account/ |
| Gift card/ Gift voucher | Gift card/ Gift voucher/ FreeCharge Balance |
* Some partners may offer you the option to pay with a credit/debit card upon delivery/pickup. Refunds for such payments will be via NEFT transfer to your bank account
- We may request for information/documents to verify your credentials before initiating the refund.
- If the payment mode has expired or is no longer valid, we will refund you one of the modes mentioned above.
How can I learn about changes to this Privacy Policy?
If we decide to modify this Privacy Policy, we will highlight the changes for a reasonable period of time.
Where can I go with questions?
If you have any questions about this Privacy Policy or our information practices, please contact us at info@laboratorydeal.com